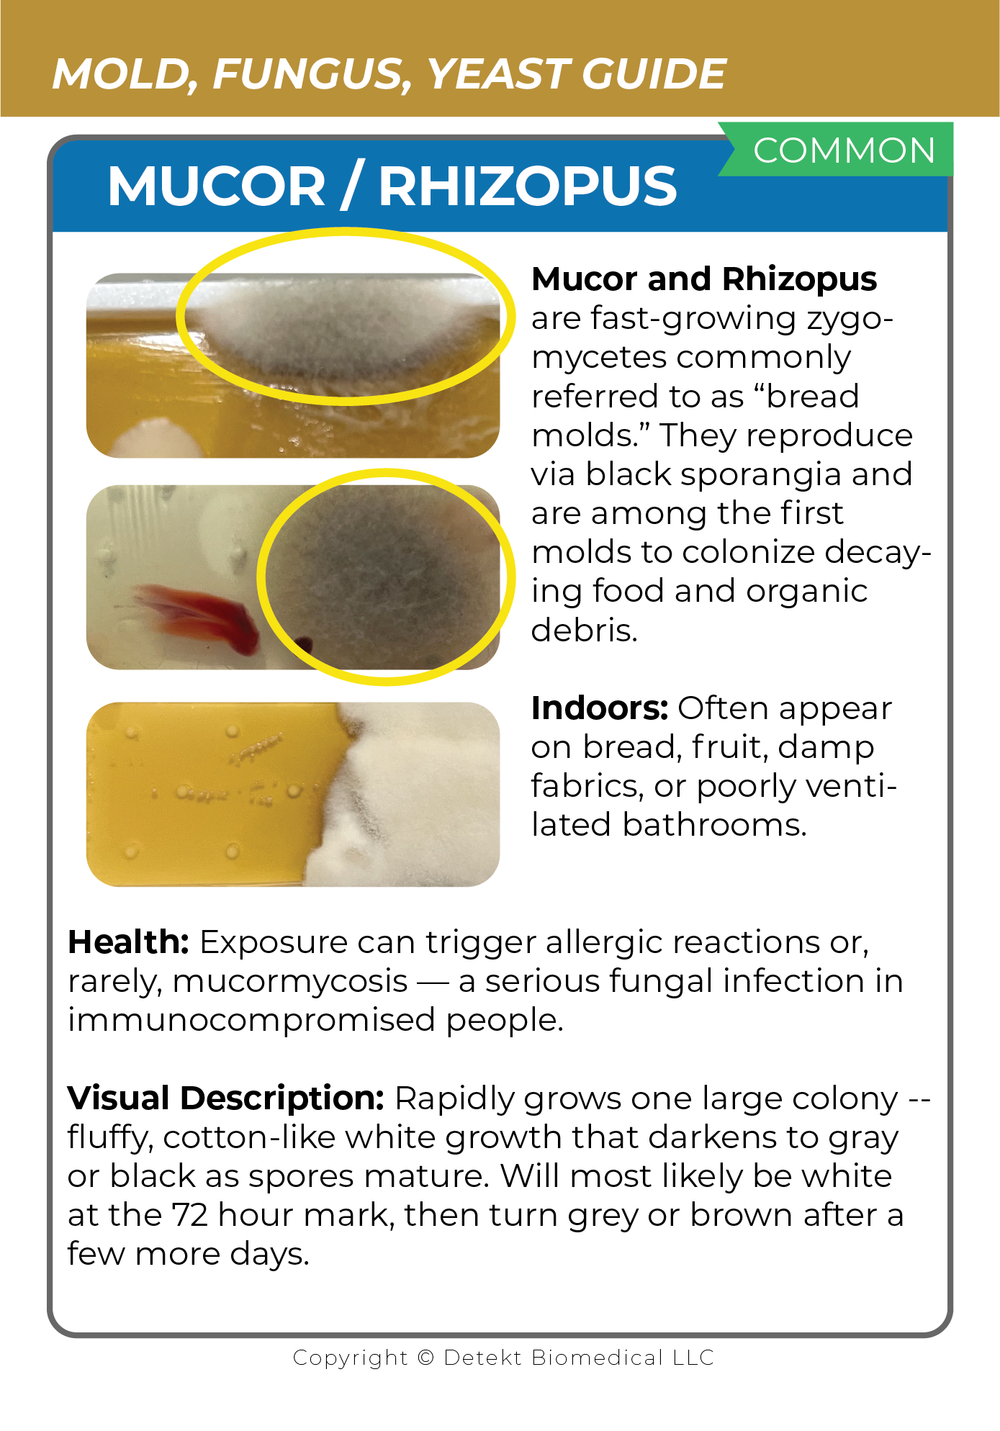
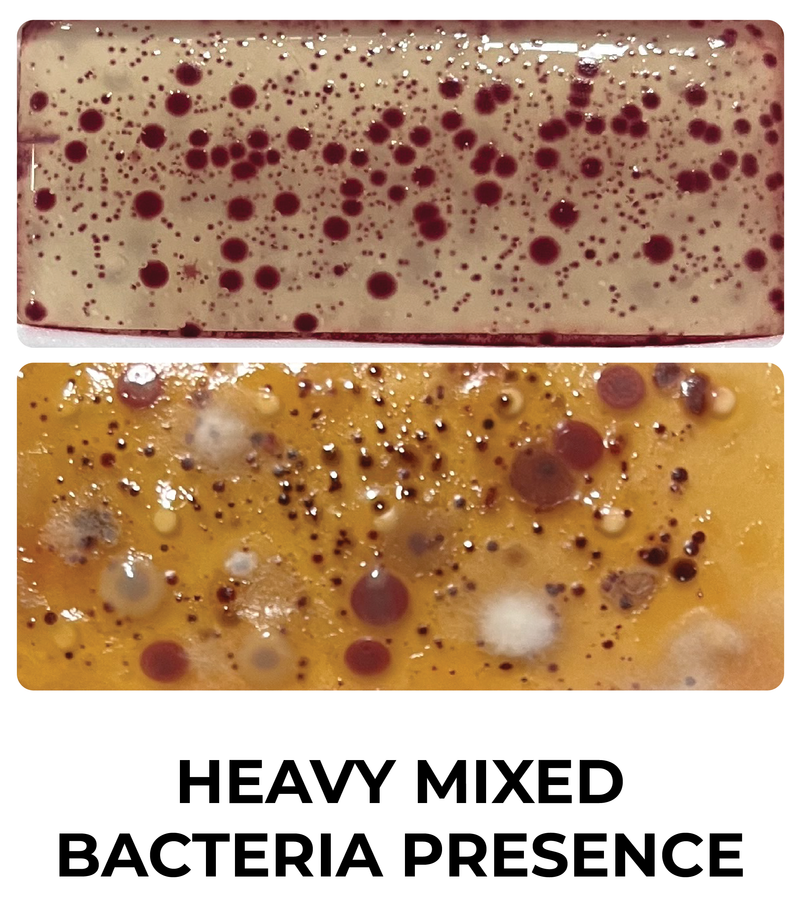
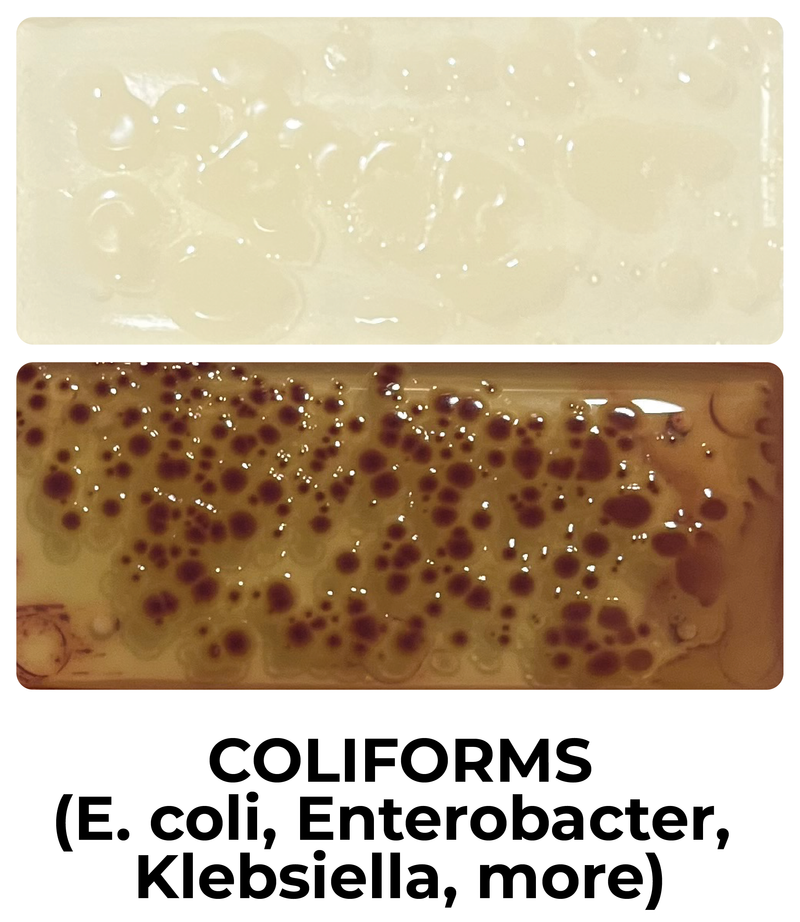
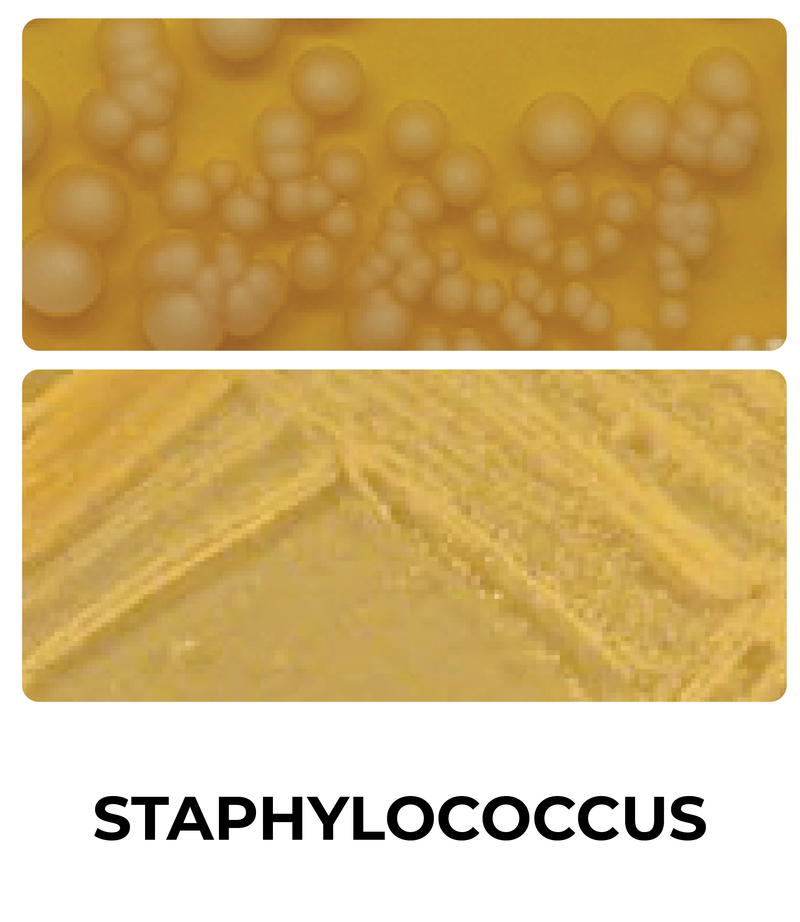
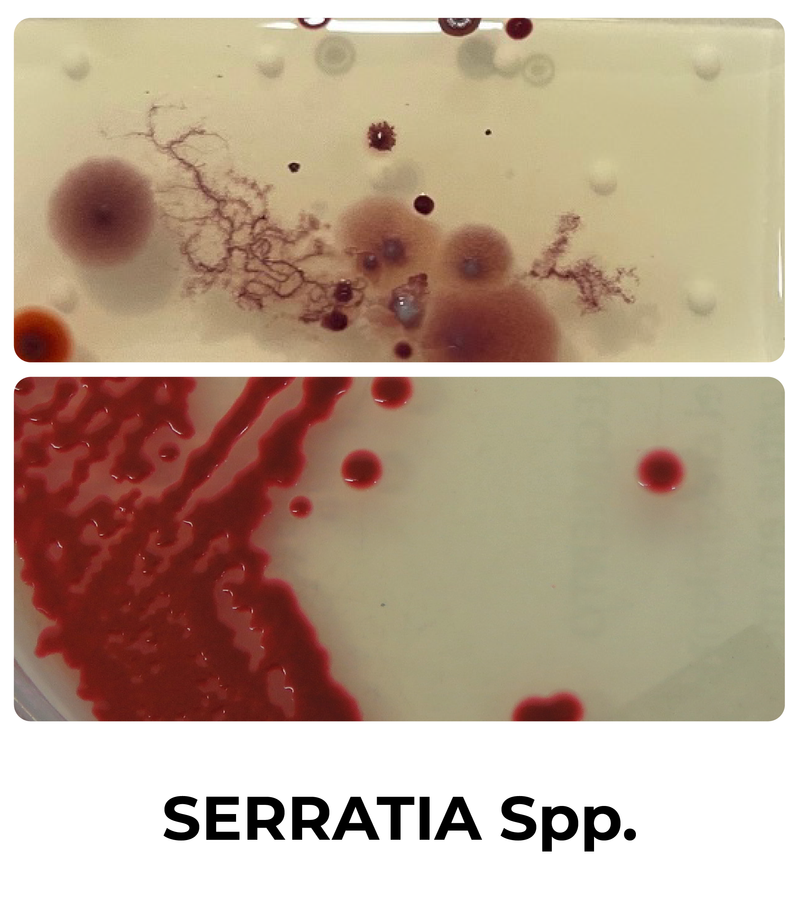
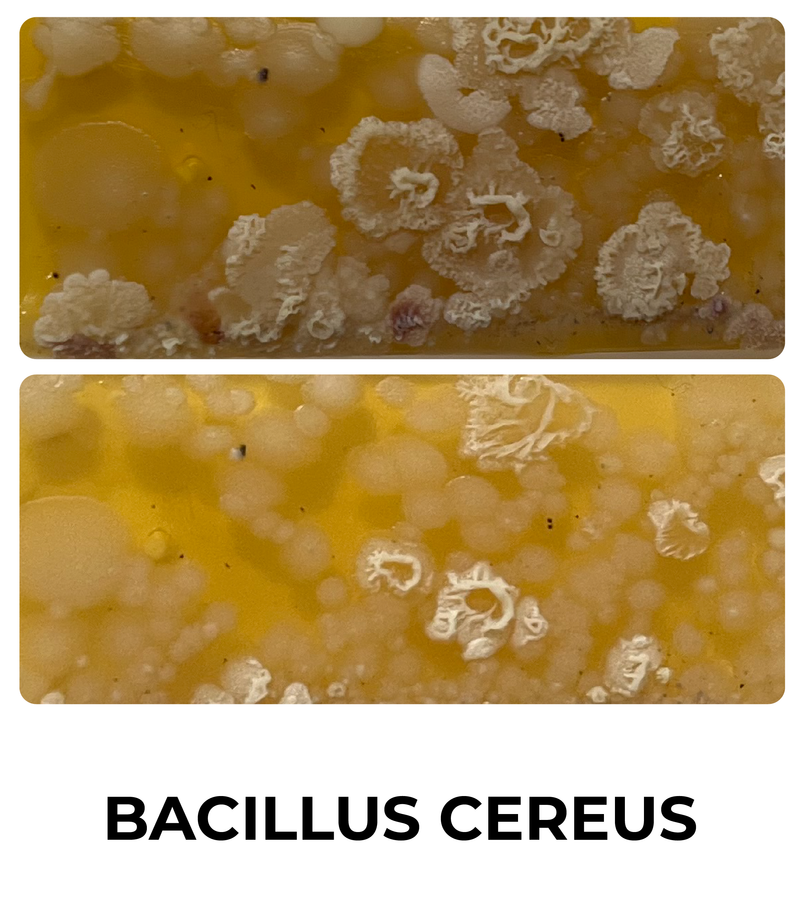
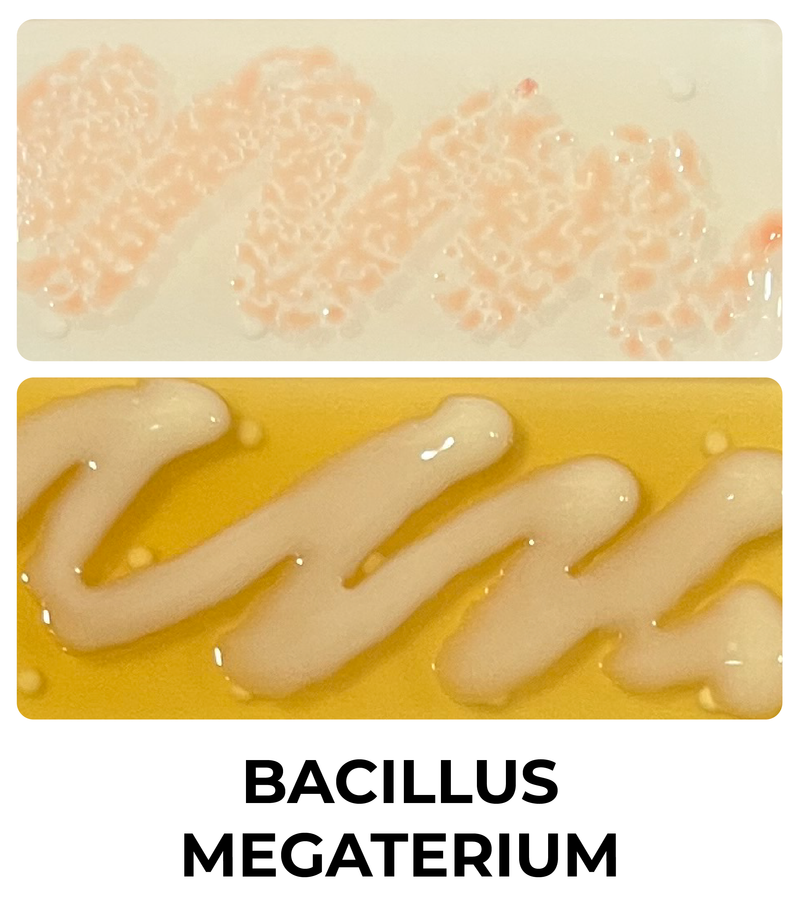
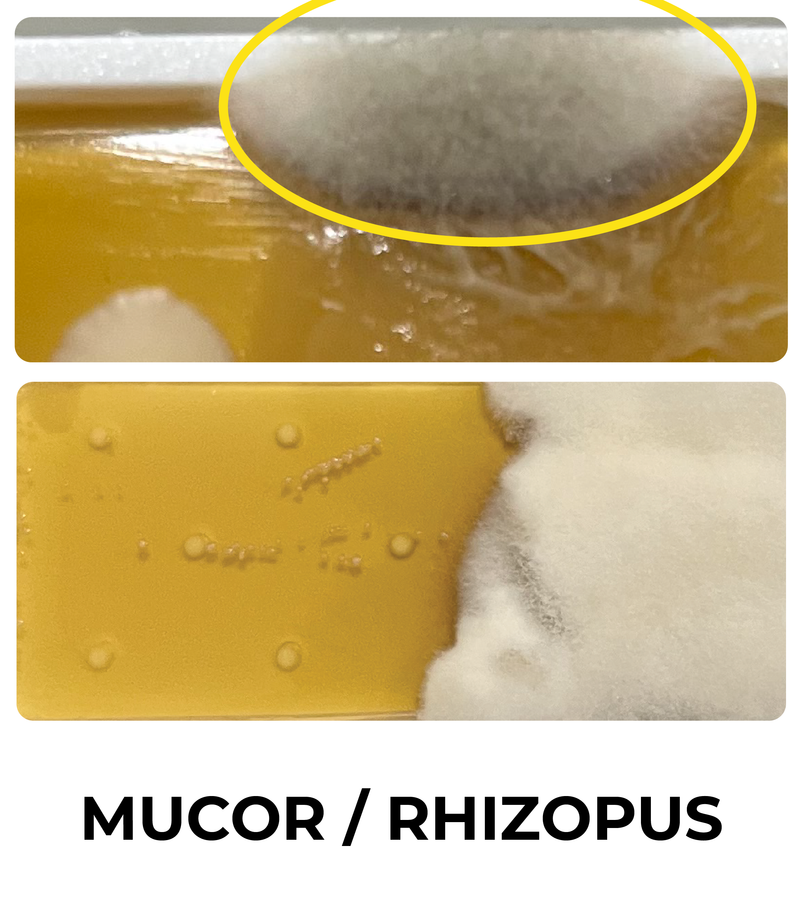
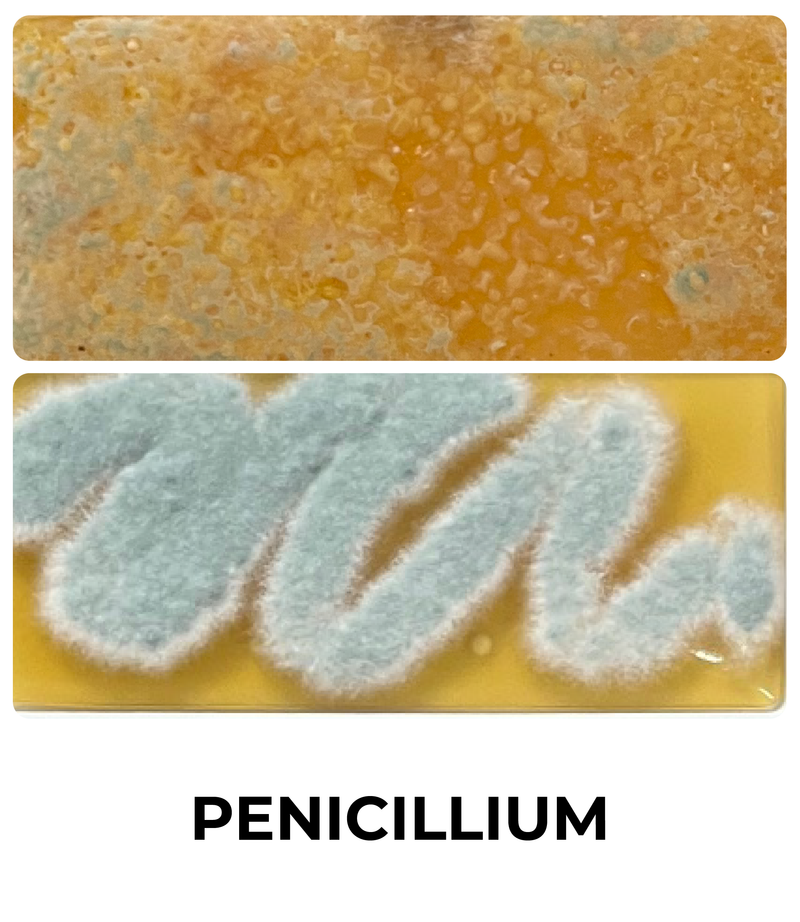
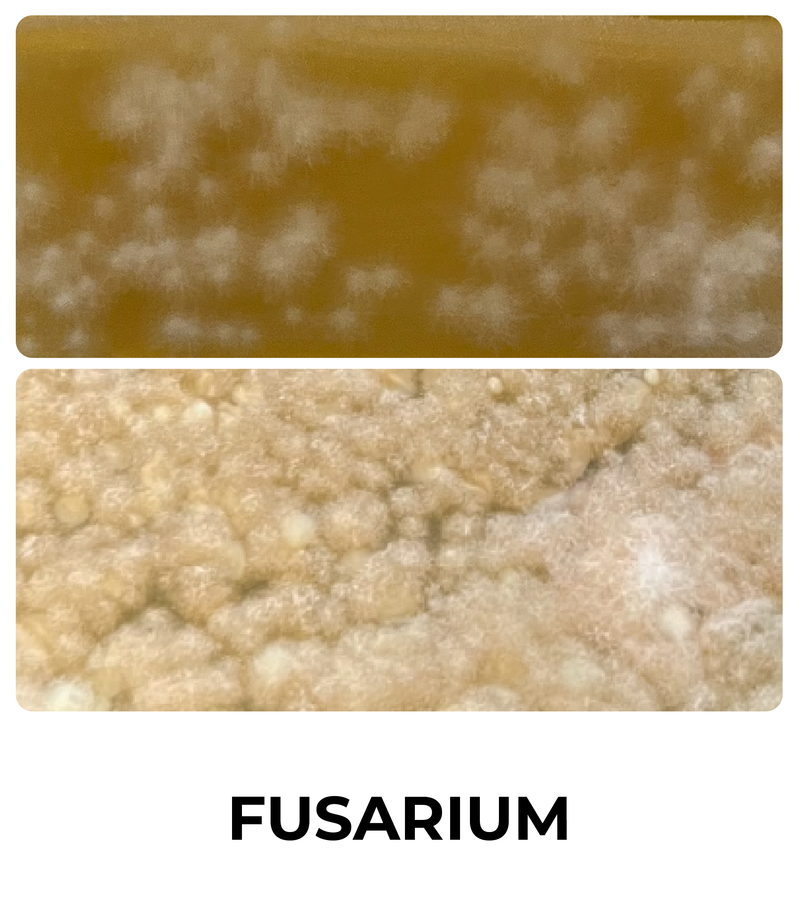
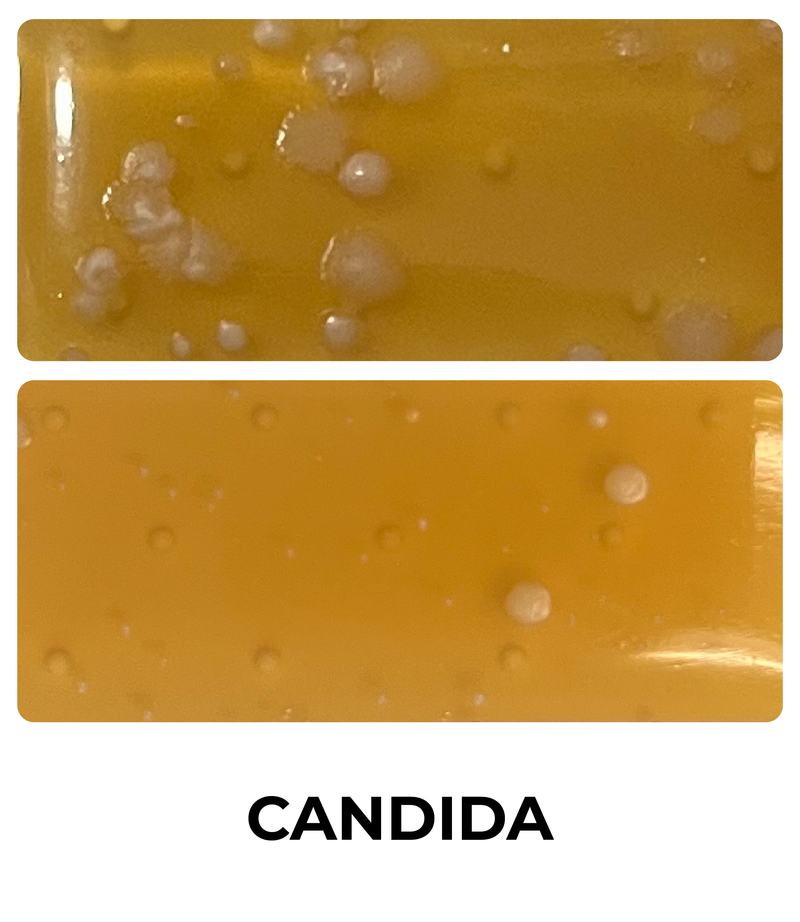
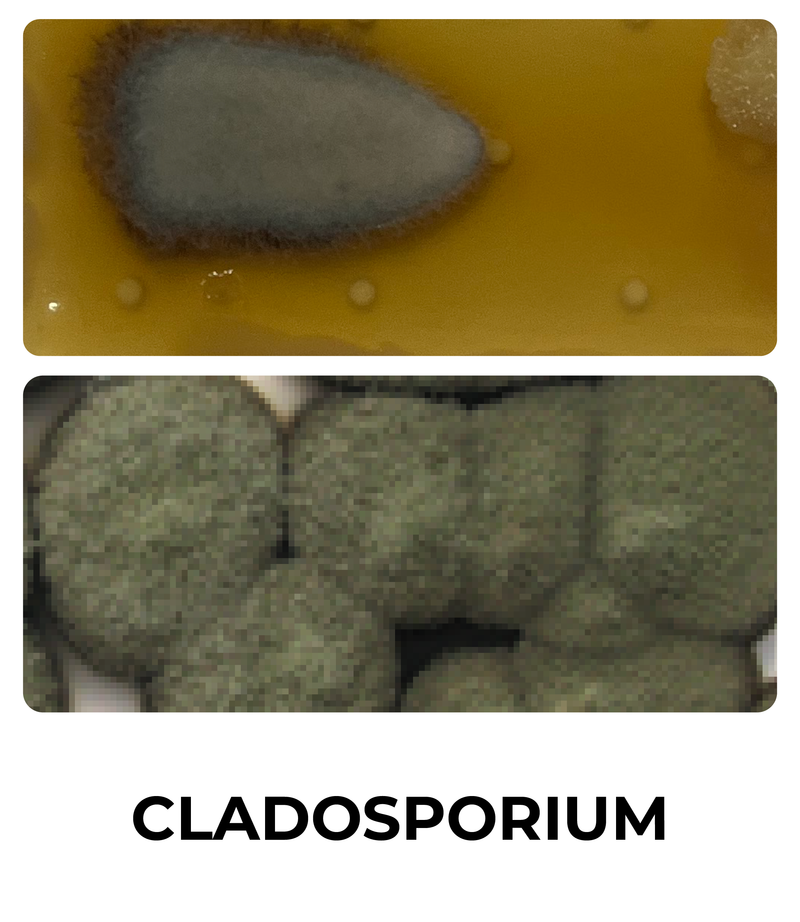
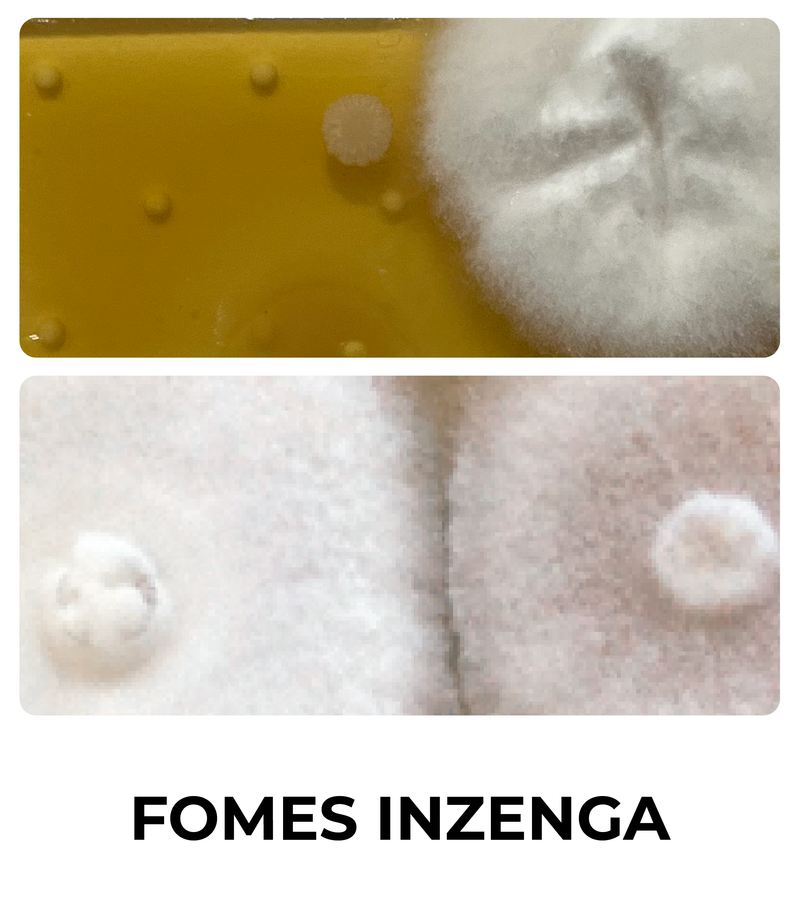
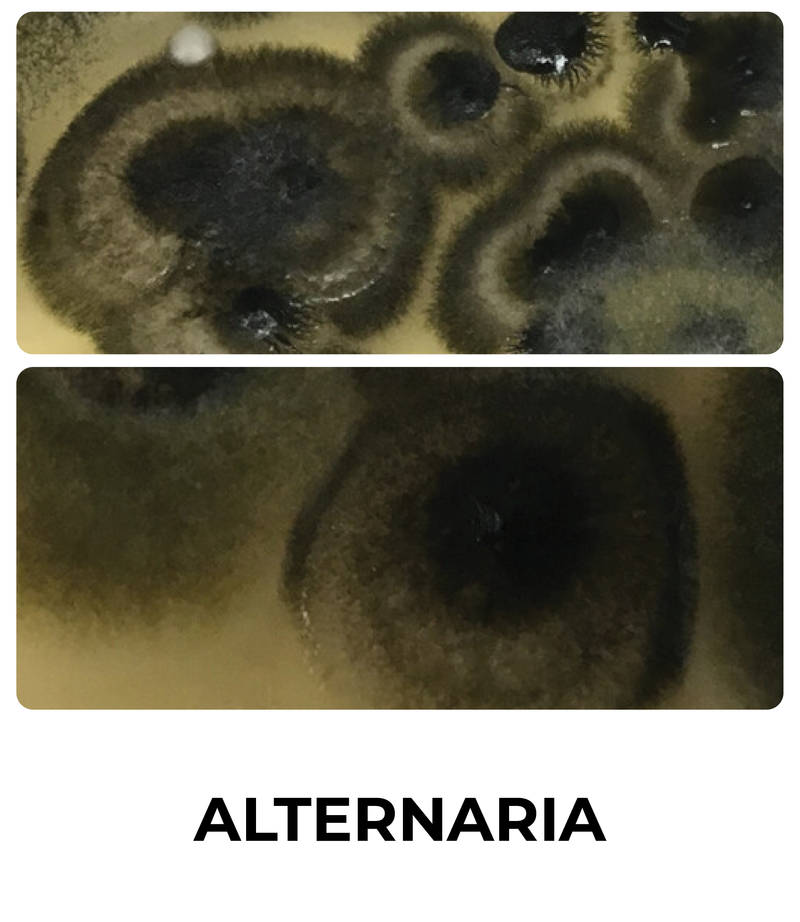
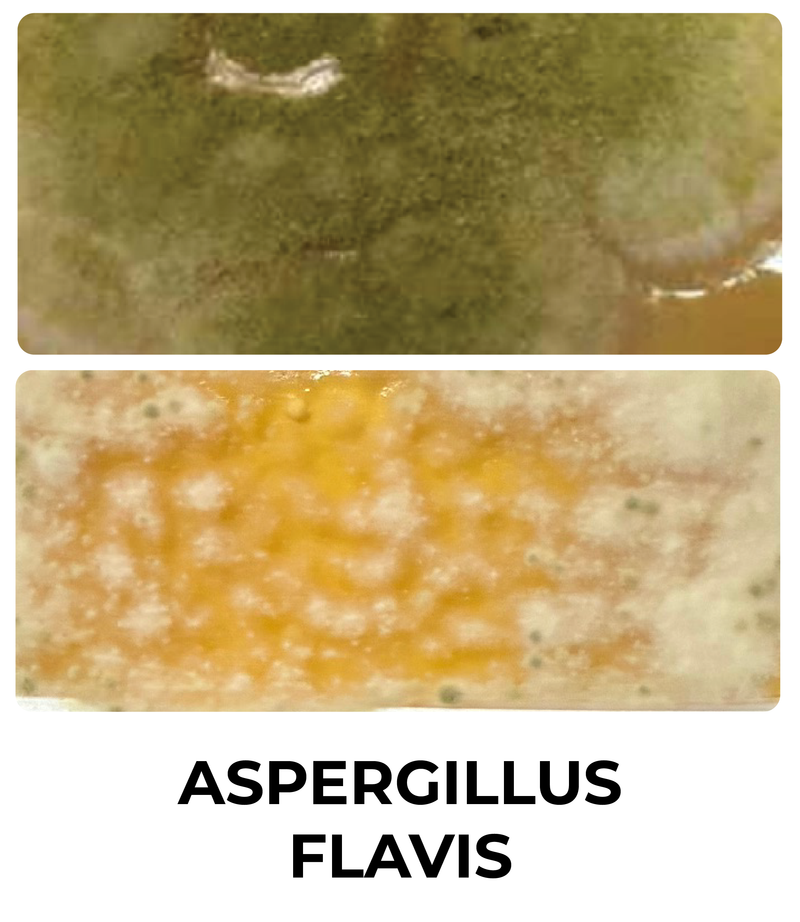
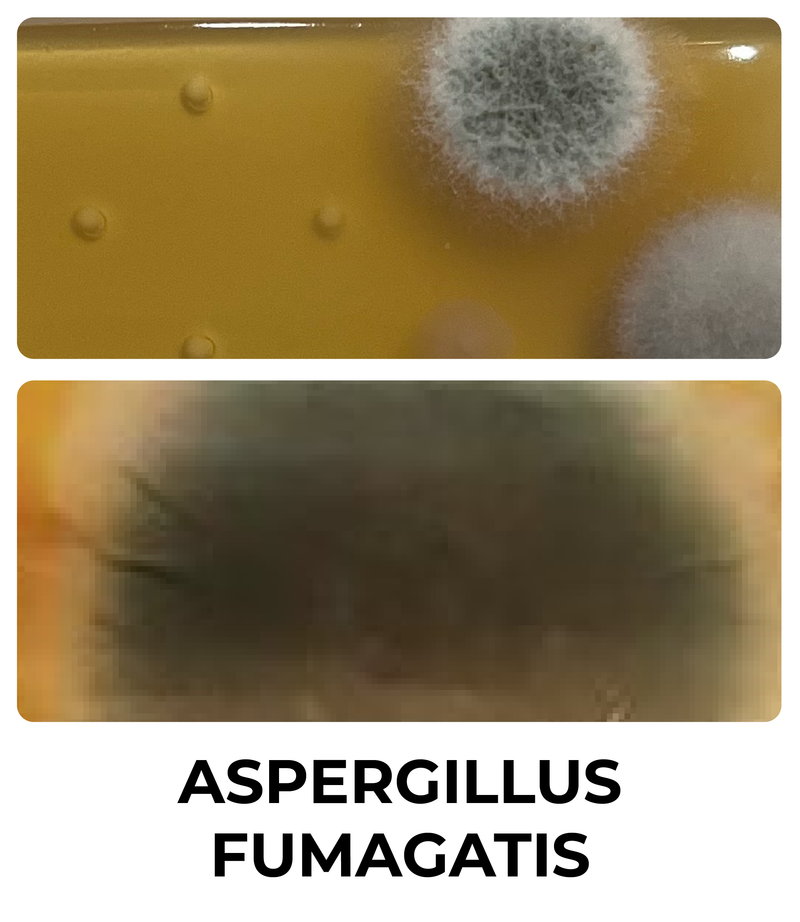
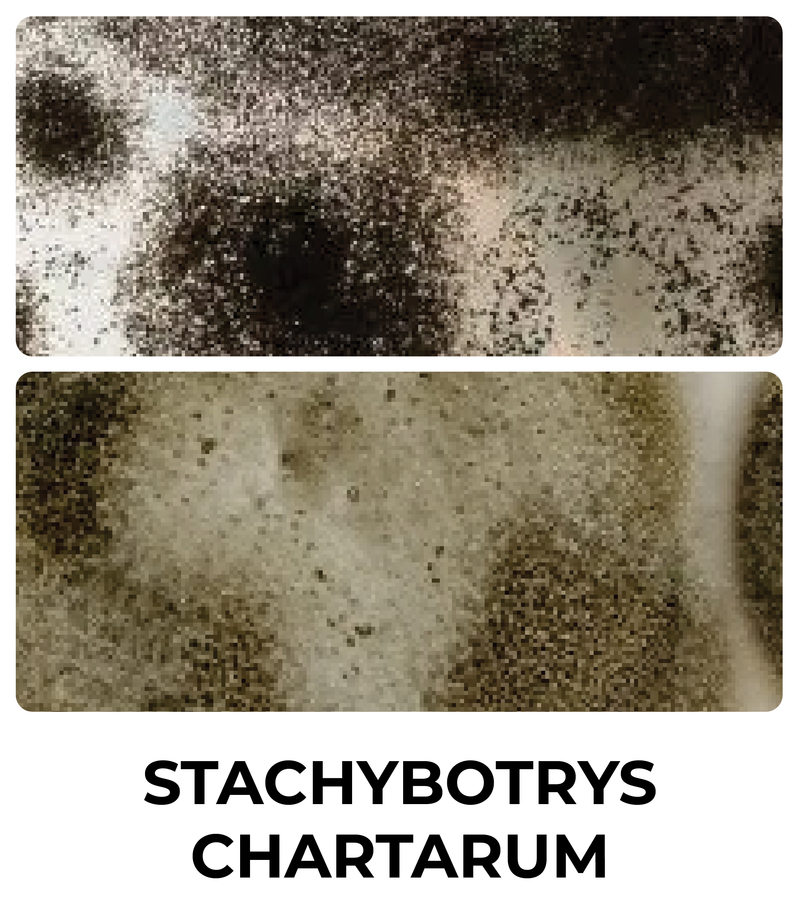
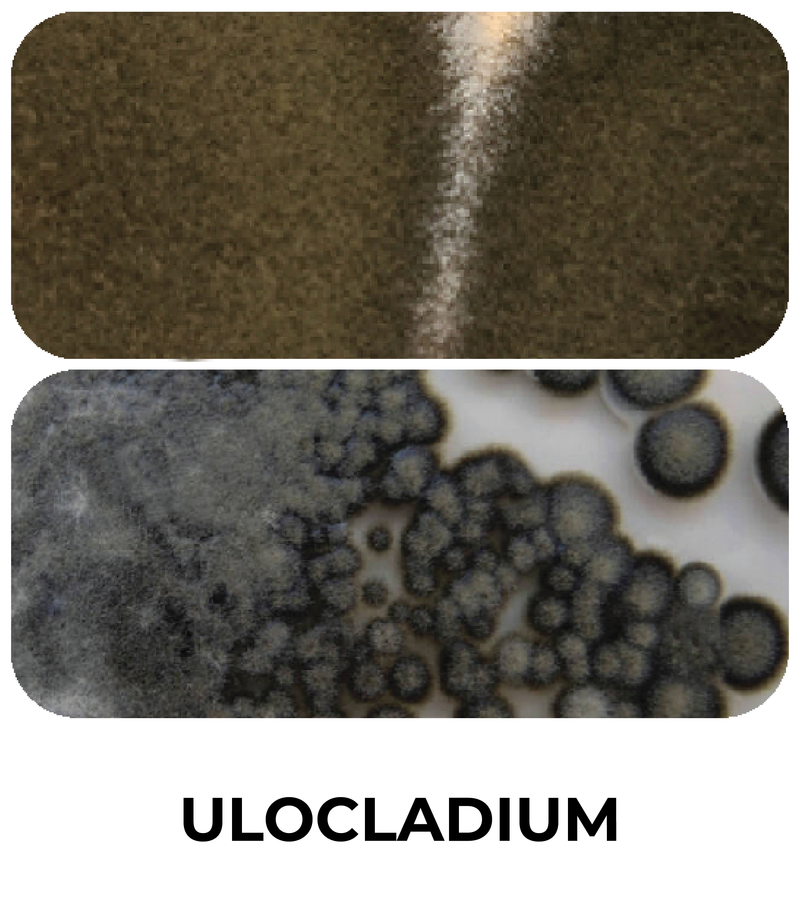
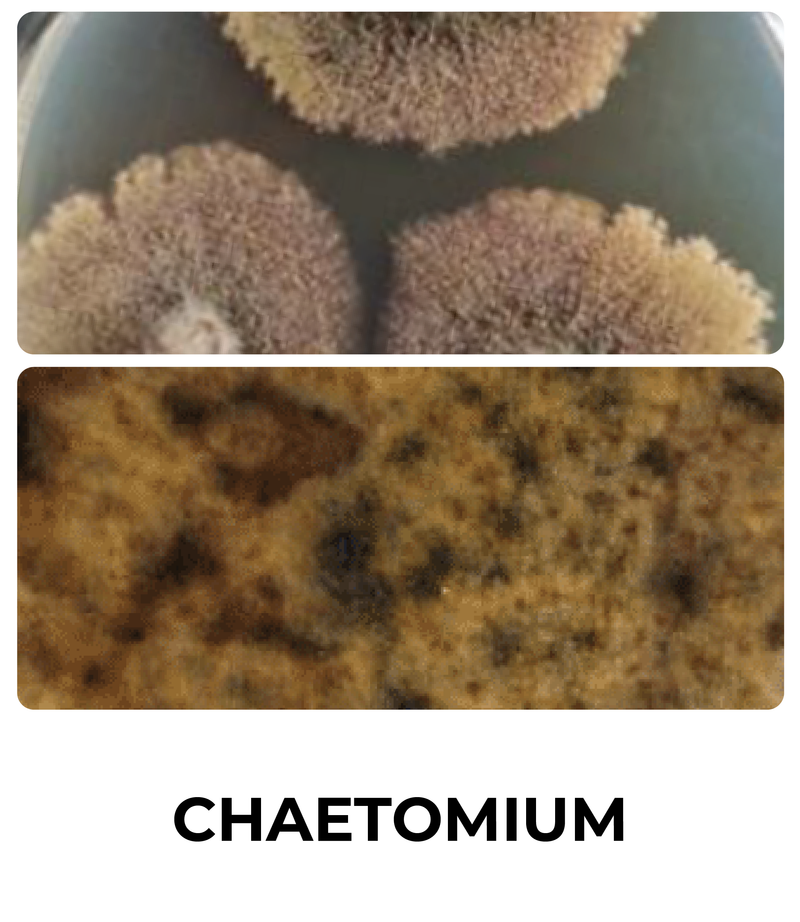

Mold & Bacteria Species Guide
Rated Amazon's #1 Mold Guide - Developed by our scientists in Austin, Texas.
Quick Guide
See more information on species, visual descriptions, hazards, and common locations in the manual below.
In-Depth Bacteria Species

Page 1

Page 2
In-Depth Fungus & Mold Species

Page 1
Page 2